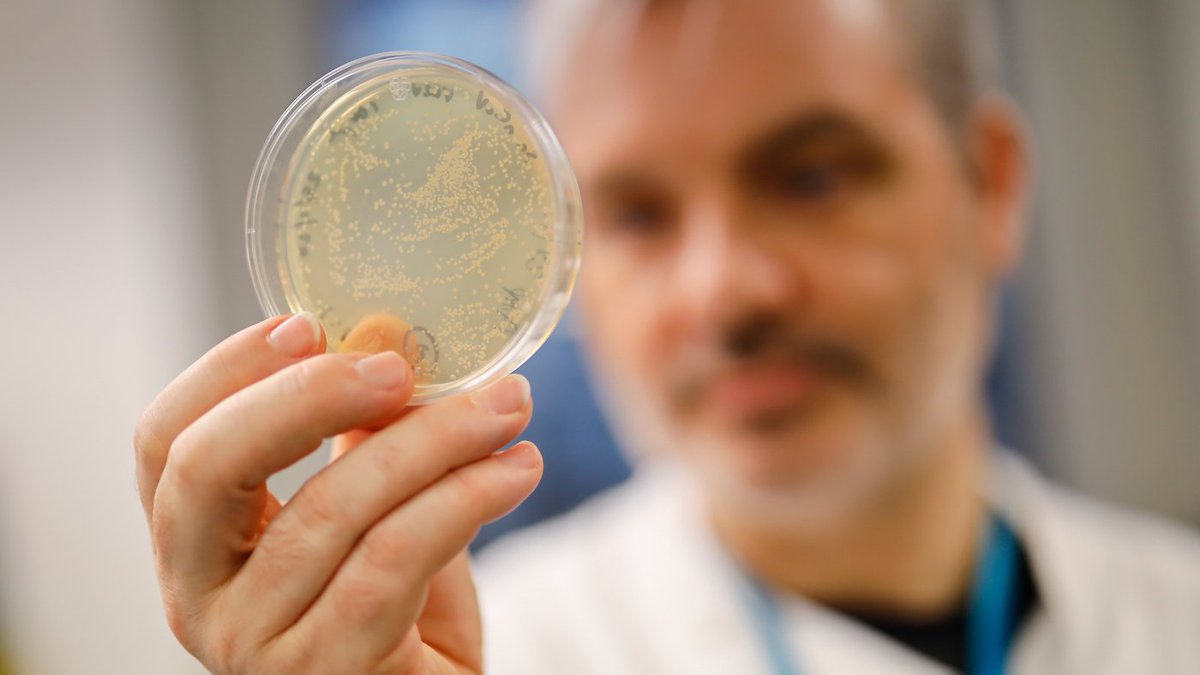

شرحی مختصر و غیر تخصصی بر واکسن ویروس ضعیف شده و نحوه ساخت آن
1) تمرکز بنده بیشتر بر روی مسائل امنیتی-نظامی است. اما با توجه به اهمیت بحث روز واکسن ایرانی کرونا توضیحی مختصر و غیر تخصصی در باب واکسن ویروس ضعیف شده ارائه میدهم. واکسن ایرانی کرونا طبق اعلام متولیان #رشتو کوتاه🦠💉
1) تمرکز بنده بیشتر بر روی مسائل امنیتی-نظامی است. اما با توجه به اهمیت بحث روز واکسن ایرانی کرونا توضیحی مختصر و غیر تخصصی در باب واکسن ویروس ضعیف شده ارائه میدهم. واکسن ایرانی کرونا طبق اعلام متولیان #رشتو کوتاه🦠💉

2) امر از نوع واکسنهایی است که از تکنیک ویروس ضعیف شده بهره میبرد این شیوه ساخت واکسن قدمتی طولانی دارد اما این روش همچنان کارکرد موثر و خوب خود را حفظ کرده است و به نسبت روش ساده تری از روش جدیدتر فایزر است. در این تکنیک ویروس زنده اصطلاحا ضعیف شده به بدن بیمار تزریق میشود اما 

3) این ویروس سرعت تکثیر کندتری تری نسبت به ویروس بیمارزای اصلی دارد و این به بدن فرد فرصت میدهد تا ویروس را با فرصت شناسایی و آنتی بادی مناسب را در برابرش تولید کند. اما چگونه این ویروس ضعیف شده ساخته میشود. در ابتدا نیاز به یک محیط تکثیر مناسب داریم. تخم مرغ نقش مهمی در این 

4) میان بازی میکند اما نه تخم مرغی که در خانه مصرف میکنید تخم مرغ نطفه داری که حاوی سلولهای جوجه است. در دمای مناسب ویروس به آن تزریق و نگهداری میشود. ویروس با سلولهای موجود در تخم مرغ درگیر میشود و در آن تکثیر میشود. اما ویروس برای سازگاری با سلول جدید جوجه بخشی از محتوای ژنتیکی 

5) خود را تغییر و با محیط جدید سازگار میشود و در دامی که سازندگان واکسن میخواهد می افتد و با تغییرات جدید و شاید چند باره در محیط تخم مرغ تکثیر میشود. سازندگان ویروس جدید را استخراج میکنند و برای آزمایشات ویروس را به حیوانات و انسان را تزریق میکنند. ویروسی که با سلولهای به اصطلاح 

6) جوجه سازگار شده است وقتی وارد بدن انسان میشود نمیتواند به سرعت خود را تکثیر کند و بدن انسان فرصت دارد تا راه مقابله با آن را یاد بگیرد، که به این ویروس ویروس ضعیف شده میگوییم. شکل ضعیف شده ویروس هم شباهت کافی به ویروس اصلی دارد و بدن خودش را در برابر نوع اصلی ایمن خواهد کرد. 

7) البته این بحث ریز جزئیات تکنیکی فراوانی دارد اما به طور خلاصه اصول آن این است.این ساده ترین توضیحی بود که میتوان داد
در فضایی که وجود دارد. مقایسه ساخت واکسن و ساخت خودرو (پراید...) چندان همخوان نیست. احتمالا ساخت اتوموبیل خوب از ساخت بسیاری از واکسنها بسیار بسیار سخت تر باشد.
در فضایی که وجود دارد. مقایسه ساخت واکسن و ساخت خودرو (پراید...) چندان همخوان نیست. احتمالا ساخت اتوموبیل خوب از ساخت بسیاری از واکسنها بسیار بسیار سخت تر باشد.
8) مثلا موسسه واکسن و سرم رازی نزدیک به یک قرن سابقه دارد و در دورانی تاسیس شده است که احتمالا کشور ما در ابتدای گذار به مدرنیته میل لنگ خودرو را هم نمیتوانست تولید کند. اما در مجموع باید تا مشخص شدن وضعیت واکسن ایرانی واکسن خرید چون ساخت و تست تا تولید صنعتی تفاوتها دارد 🦠💉 

• • •
Missing some Tweet in this thread? You can try to
force a refresh

























